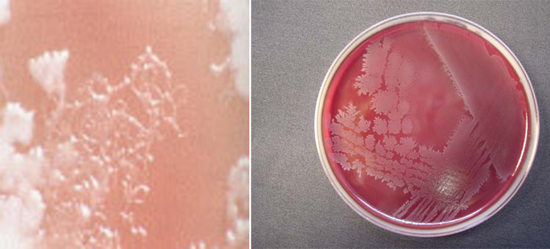

И влажная форма
Влажная гангрена (в народе иногда ее называют мокрой) отличается более тяжелым, чем сухая, течением. Она развивается в тканях, богатых жидкостью в силу множества причин, приводящих к нарушению целостности не только клеток и тканей организма, но порой и целых органов. Стартом возникновения влажной гангрены служит внезапное (острое) нарушение кровообращения. Например, ущемленная грыжа или мезотромбоз кишечника могут в кратчайшие сроки привести к такому виду некроза, который принято считать самым грозным (и часто смертельным) осложнением основного заболевания.
рисунок: влажная гангрена внутренних органов на примере гангрены легких
Начальная стадия может пройти стремительно, например, при гангрене нижних конечностей она будет выглядеть следующим образом:
- Места поражения сильно отекают, снижается температура и бледнеет кожа, она быстро приобретает мраморный оттенок, а затем покрывается темно-красными пятнами и пузырями, которые, вскрываясь, выделяют жидкость с примесью крови;
- На пораженных участках отчетливо выступает венозная сеть;
- Периферические артериальные сосуды не прощупываются, пульс исчезает;
Для «мокрой» формы характерны следующие признаки:
- Высыхание тканей не происходит, а наоборот: пораженные участки чернеют, происходит распад тканей с образованием серо-зеленой зловонной массы;
- Формируются гнилостные очаги, выделяющие большое количество токсических веществ, которые быстро всасываются в кровь;
- Наблюдается тяжелое отравление организма (интоксикация), которое заметно ухудшает состояние пациента;
- В некротических очагах активное размножение начинает условно-патогенная и патогенная флора;
- Некроз стремительно захватывает новые территории, не формируя границу между здоровыми и пораженными тканями.
Влажная гангрена чаще грозит людям отечным, имеющим лишнюю массу тела. При попадании в рану гнилостной флоры, в частности, клостридий, широко распространенных в природе, влажная гангрена может перейти в газовую.
Газовая гангрена является серьезным инфекционным заболеванием, вызванным анаэробными бактериями, чаще всего Clostridium perfringens. Врачи отмечают, что основными причинами развития этой патологии являются травмы, хирургические вмешательства и наличие хронических заболеваний, таких как диабет. Симптомы газовой гангрены включают резкую боль в пораженной области, отек, изменение цвета кожи и образование пузырей с газом. Важно отметить, что заболевание быстро прогрессирует и может привести к серьезным осложнениям, включая ампутацию конечностей. Лечение требует немедленного вмешательства, включая хирургическое удаление некротических тканей, антибиотикотерапию и, в некоторых случаях, гипербарическую оксигенацию. Врачи подчеркивают важность ранней диагностики и своевременного лечения для повышения шансов на успешное выздоровление.

Симптомы газовой гангрены
Для газовой гангрены характерно раннее бурное начало. Симптомы обычно появляются на 1-3 день после травмы. Ткани вокруг раны отекают, появляется зловонное отделяемое с пузырьками газа. Отек стремительно распространяется на соседние участки, состояние больного быстро ухудшается, отмечаются признаки отравления организма продуктами распада тканей. Без специализированной медицинской помощи смерть наступает в течение 2-3 суток с момента начала болезни.
Особенности местных и общих проявлений зависят от вида возбудителя. Для Clostridium perfringens характерно фибринолитическое, токсико-гемолитическое и некротическое течение, для Clostridium septicum – серозно-кровянистый отек тканей, малое количество выделяемого газа и интенсивное разрушение эритроцитов. Clostridium oedematiens, напротив, образует большое количество газа и при этом также оказывает гемолитическое воздействие на организм. Clostridium histolitycum отличается особой агрессивностью по отношению к живым тканям. Всего в течение 10-12 часов она способна разрушить соединительную и мышечную ткань настолько, что будут видны кости.
Температура тела повышена до 38-40°С, отмечается снижение артериального давления, тахикардия, учащенное дыхание, жажда, озноб, мучительная бессонница, головная боль, ломота в мышцах. Пациент возбужден, говорлив или, напротив, подавлен. Постепенно развивается вначале олигурия (уменьшение количества выделяемой мочи), а затем и анурия (отсутствие мочи). В тяжелых, прогностически неблагоприятных случаях возможно понижение температуры тела и гематурия.
Разрушение эритроцитов становится причиной быстро развивающейся анемии и гемолитической желтухи. В анализах крови выявляется снижение количества эритроцитов, снижение уровня гемоглобина, лейкоцитоз со сдвигом формулы влево и преобладанием юных форм нейтрофилов. К числу наиболее постоянных местных симптомов относится отек окружающих тканей, образование газа, разрушение мышечной ткани и отсутствие классических признаков воспаления.
С учетом местных проявлений выделяют четыре формы газовой гангрены.
Классическая или эмфизематозная форма. Наблюдается умеренный отек, постепенно сменяющийся омертвением тканей с выделением большого количества газа. Гной отсутствует. Раневая поверхность сухая, выявляются обширные очаги некроза. Грануляций нет, на дне виднеется омертвевшая серо-зеленая, не кровоточащая мышечная ткань с трупным запахом. При надавливании из раны выделяется газ и сукровичная жидкость. Кожа в зоне поражения холодная, бледная, покрытая буроватыми пятнами. По мере прогрессирования инфекции боли в ране сначала резко усиливаются, затем чувствительность теряется. Пульс на периферических артериях исчезает, конечность приобретает бурую окраску и омертвевает.
Отечно-токсическая форма. Сопровождается обширным, быстро распространяющимся отеком, нарастающим буквально в течение каждой минуты. Рана без гнойного отделяемого, газ выделяется в малых количествах или отсутствует. Из-за быстро нарастающего отека мышцы сдавливаются и выбухают из раны. Подкожная клетчатка зеленоватая, желеобразная, мышечная ткань бледная, кожные покровы вокруг раны холодные, блестящие, резко напряженные. По мере развития воспаления периферический пульс исчезает, конечность становится бурой, развивается омертвение.
Флегмонозная форма. Протекает более благоприятно, может быть развиваться на ограниченном участке. Отек окружающих тканей умеренный или незначительный, на дне раны – розовые мышцы с участками некроза. Из раны выделяется гной и пузырьки газа. Кожа вокруг раны теплая, без пятен. Пульс на периферических артериях сохранен.
Гнилостная или путридная. Развивается в результате симбиоза анаэробных и гнилостных микроорганизмов. В отличие от других форм чаще возникает не на конечностях, а на туловище. Характеризуется молниеносным течением с бурным распадом тканей. Инфекция быстро распространяется по клетчаточным пространствам, вызывая омертвение клетчатки, мышц и фасций. Из раны выделяется газ и зловонное гнилостное отделяемое с кусочками разрушенных тканей. Присоединение гнилостной инфекции обуславливает разрушение стенок сосудов, поэтому при этой форме газовой гангрены часто наблюдаются вторичные кровотечения.
Симптомы и признаки газовой гангрены
Развитие той или иной клинической формы газовой гангрены напрямую зависит от специфичности возбудителя. При попадании на раневую поверхность клостридии perfringens развиваются токсико-гемолитические, фибринолитические и некротические изменения. Такой возбудитель газовой гангрены как Cl. septicum провоцирует развитие кровянисто-серозного отека мягких тканей с минимальной продукцией газа в межмышечных пространствах, а продукция экзотоксинов сопровождается гемолизом эритроцитов.
В экспериментальных условиях были определены такие свойства токсинов Cl. septicum как склонность к снижению артериального давления, развитие нарушения ритмичности сердечной деятельности. Особенностью Cl. oedematiens является его способность провоцировать быстрое нарастание отека мягких тканей, что сопровождается выделением газа. Самым агрессивным в отношении деструктивного воздействия на мягкие ткани человеческого организма является Cl. Histolitycum, который в течение 10 — 12 ч. способен полностью расплавлять мышечный массив и связочный аппарат конечностей, вплоть до скелетирования костей.
Классический вариант течения клинической картины газовой гангрены состоит из проявлений местного и общего характера. Учитывая особенности местных симптомов выделяют несколько клинических форм газовой гангрены. Так, классической формой заболевания является эмфизематозная, патоморфологическим субстратом которой является развитие местного отека мягких тканей, их разрушение и выраженное локальное газообразованием. Раневая поверхность при газовой гангрене остается сухой и не имеет признаков грануляции, однако характеризуется образованием обширных некрозов. При осуществлении пальпации пораженной области, отмечается выделение сукровичной жидкости и пузырьков газа, а кожные покровы вокруг имеют белесоватый окрас. Впоследствии мышечная ткань приобретает серо-зеленую окраску, что сопровождается выраженным болевым синдромом и исчезновением пульса на периферических артериях. Прилегающие к раневой поверхности кожные покровы багровеют, чувствительность в пораженной области полностью отсутствует. Для данной формы газовой гангрены не характерно образование гноя.
Начальными проявлениями отечно-токсической формы газовой гангрены является формирование обширной зоны отека мягких тканей при полном отсутствии газо- и гноеобразования. В результате нарастающего отека происходит увеличение в объемах мышечного массива, который имеет бледную окраску и выбухает из раневой поверхности. Характерным проявлением отечно-токсической формы газовой гангрены является изменение окраски и структуры подкожно-жировой клетчатки, которая имеет студенисто-желеобразный вид. При нарастании отека происходит развитие нарушений кровоснабжения и развивается массивное омертвение мягких тканей.
Флегмонозная газовая гангрена является самой благоприятной клинической формой, так как при ней патологические изменения мягких тканей носят ограниченный характер. Отличительной особенностью данного варианта течения газовой гангрены является образование гнойного отделяемого в ране. Распространение воспалительного процесса происходит по межмышечным пространствам, причем практически никогда не наблюдается нарушения кровоснабжения пораженной области.
Для путридной или гнилостной газовой гангрены характерно бурное нарастание клинической симптоматики, что обусловлено массивным некротиизированием мягких тканей. Распространение патологического процесса происходит не только по клетчатке, но и по межмышечным пространствам. Некротические мягкие ткани имеют грязно-серый цвет и покрываются гнилостным отделяемым, который имеет выраженный неприятный запах. Осложнения газовой гангрены в этой ситуации обусловлены присоединением гнилостного бактериального компонента. Для данной формы газовой гангрены характерно развитие вторичных эрозивных кровотечений, которые обусловлены массивным распадом белков, которые содержатся в стенках сосудов. Локализуются патологические изменения при гнилостной форме преимущественно вблизи прямой кишки, а также парамедиастинально.
Газовая гангрена — это серьезное инфекционное заболевание, вызываемое анаэробными бактериями, чаще всего Clostridium perfringens. Люди, сталкивающиеся с этой проблемой, отмечают, что основными причинами развития инфекции являются травмы, хирургические вмешательства и наличие хронических заболеваний. Симптомы проявляются быстро: отек, сильная боль, образование пузырей с газом, а также общая интоксикация организма. Важно отметить, что при первых признаках необходимо немедленно обратиться за медицинской помощью, так как заболевание может прогрессировать в течение нескольких часов. Лечение включает хирургическое удаление некротических тканей и антибиотикотерапию. Многие пациенты подчеркивают важность своевременной диагностики и адекватного лечения для предотвращения серьезных осложнений.

Clostridium novyi
Clostridium novyi являются одним из основных возбудителей газовой гангрены. В годы Великой Отечественной войны причиной газовой гангрены в 42% случаев были бактерии этого вида. Впервые выделили возбудитель и дали ему название Clostridium oedematiens Э. Сэген и М. В. Вейнберг в 1891 году. Позже более полно этот вид клостридий был описан американским бактериологом Ф. Нови, чьим именем в дальнейшем стали называть этот вид бактерий.
Морфология Clostridium novyi
Клостридии представляют собой палочки, крупные, иногда слегка изогнутые, размером 4 — 22 х 1,4 — 2 мкм, подвижные, имеют до 25 жгутиков, располагаются часто цепочками. Возбудитель, как и все клостридии, являются облигатными анаэробами. Капсулу не образуют. Окрашиваются по Граму в фиолетовый цвет (грамположительные). Старые культуры утрачивают эту способность. Образуют овальной формы споры, располагающиеся центрально и субтерминально.
Рис. 14. Clostridium novyi. Крупные палочки, располагаются одиночно или цепочками.

Культивирование
Clostridium novyi являются строгими анаэробами. Высокочувствительны к кислороду. Растут на простых средах: углеводных, казеиновых и мясопептонных.
При росте на плотных средах через 48 часов образуются полупрозрачные, сочные колонии сероватого цвета. Края неровные. Поверхность зернистая. Клостридии типов А, В и С иногда образуют дочерние колонии. Колонии окружены зоной гемолиза. Клостридии типа D эритроциты не разрушают.
В глубине агара колонии напоминают комочки ваты или снежные хлопья, часто окрашенные в коричневый или желтый цвет.
При росте на жидких средах образуется газ и помутнение питательной среды, на дно выпадает осадок. рН сдвигается в кислую сторону за счет образования H2S и органических кислот.
Антигенная структура
Clostridium novyi идентифицируются по выявлению соматических антигенов. Существует 4 серовара, различные по антигенным характеристикам и синтезируемых токсинов — серовары А, В, С и D.
Биохимические свойства
Серовары типов А, В и С ферментируют фруктозу, глюкозу и мальтозу, серовары типа D ферментируют только глюкозу. Серовары типов А, С и D разлагают глицерин. Все штаммы свертывают молоко и разлагают желатин. Клостридии типа D образуют сероводород и индол, остальные типы бактерий — нет.
Токсины Clostridium novyi
Clostridium novyi продуцируют такой фермент патогенности, как фосфолипазу (а-токсин), а также b, у, сигма, е и n — токсины, обладающие некротическим, гемолитическим и летальным действиями. Нарушая проницаемость сосудов, они приводят к развитию желеобразного отека.
Рис. 15. На фото газовая гангрена.
Как развивается
Клостридий широко разнесен во внешней среде, а также в почве, где существует в виде спор и проникает в организм человека посредством ссадин и царапин, если их вовремя не обработать. Основными факторами развития анаэробной инфекции газовой гангрены являются следующие показатели:
- Часто ситуация возникает при нарушении оксигенации и при плохом сообщении полости и внешней среды. Также поражение формируется при длительном ношении кровоостанавливающего жгута на конечностях при ранении магистрального сосуда и у пациентов, у которых присутствует хроническая артериальная недостаточность.
- Благоприятным фоном выступает наличие значительной массы ушибленных и разможенных тканей, а также факторов, которые понижают сопротивляемость организма.
- Возбудитель газовой гангрены активизируется при образовании положительных анаэробных условий. Микроорганизмы начинают энергично размножаться и формировать токсины, которые оказывают повреждающее действие на ткани, а также способствуют быстрому распространению некроза.
- Из-за сахаролитической функции рушится гликоген, а пролетическое действие приводит к расплавлению и разрушению белков.
- Клостридии отличаются образованием отеков и газов.
- Из-за действия токсина формируется тромбоз артерий и вен, происходит паралич и разрушение проницаемости сосудов.
- Ферментные элементы крови и плазма поступают в зону некроза, чем вызывается быстрое поглощение бактериальных токсинов, а продукты распада приводят к тяжелой степени интоксикации.
- Инкубационный период составляет от пары часов до 2-3 недель. В среднем это время занимает 1-7 дней, и чем срок короче, тем неблагоприятнее и тяжелее течение и прогноз.
Клостридии выделяют состоящие из нескольких фракций экзотоксины, обладающие местным и системным влиянием, к которым относят:
- лецитиназу С – имеет гемолитическое и некротическое действие;
- коллагеназу – блокирует белковые структуры;
- гемолизин – оказывает кардиотоксическое и некротизирующее влияние;
- фибринозолин;
- гиалуронидазу – является фактором проникновения бактерии;
- гемагглютинин – ингибирует образование фагоцитоза;
- нейраминидазу — нейтрализует иммунные рецепторы на эритроцитах.
Симптомы
Специфическим признаком считается крепитация – при пальпации можно ощутить похожие на хруст снега звуки. Чаще всего начало заболевания проходит бурно со значительным развитием тяжелой интоксикации. Классическими симптомами газовой гангрены являются:
- выраженный отек, проходящий без гиперемии;
- пузыри, в которых находятся геморрагические составы, а еще наблюдаются зеленые пятна на коже;
- значительные распирающие боли;
- массовый некроз мышечных и соединительных тканей;
- понижение температуры;
- формирование мутного экссудата негнойного проявления, сопровождающегося неприятным запахом;
- скопление газов.
Для анаэробной инфекции типично быстрое усиление местных симптомов газовой гангрены, а также распространенные процессы по всей области конечности. По истечении нескольких суток, как правило, начинает присоединяться и аэробная микрофлора, сопровождающаяся гнойной инфекцией.
Clostridium septicum
Clostridium septicum впервые были описаны в 1877 году Л. Пастером. Эти бактерии являются условно-патогенными. В обычных условиях они пребывают в кишечнике человека и не вызывают заболевание. В случае дефектов кишечника, например при колоректальном раке, инфекция повреждает кишечник и с кровью (гематогенным путем) распространяется по организму. В отличие от Clostridium perfringens газовая гангрена может возникнуть без предварительных травм и повреждений. Инфекция чаще встречается у людей с травмами и ожогами кожи, после хирургических вмешательств и септических абортах, заболеваниях периферических сосудов, сахарном диабете, раке толстой кишки.
Заболевание развивается быстро. До 80% взрослых погибает в течение первых 2-х суток. Выживаемость повышается у лиц без сопутствующих заболеваниях нижних конечностей.
Clostridium septicum поражают как человека, так и домашних животных: крупный и мелкий рогатый скот.
Морфология
Clostridium septicum представляет собой бактерию палочковидной формы. с размерами 3 — 4 х 1,1 — 1,6 мкм. В культурах иногда образуются нитевидные формы бактерий, имеющие в длину до 50 мкм в длину. Подвижны (имеют жгутики). Капсулу не образуют. Грамположительны. Со временем клостридии теряют эту особенность. Являются строгими анаэробами.
Clostridium septicum образуют споры. Споры чаще всего располагаются субтерминально, реже — центрально.
Рис. 16. Clostridium septicum под микроскопом.
Культуральные свойства
Clostridium septicum хорошо растут на казеиновых и мясных средах с добавлением глюкозы.
- На поверхности глюкозокровяного агара бактерии образуют полупрозрачные колонии, блестящие, состоящие из переплетающихся нитей с зоной гемолиза по периферии.
- При росте на 2% агаре колонии имеет вид дисков.
- При росте на агаре Цейсслера по истечении 48 часов образуется сплошной нежный налет с зоной гемолиза по периферии.
- При росте в 1% сахарном агаре колонии образуются в глубине. У них уплотненный центр, от периферии отходят переплетающиеся нити.
- При росте на мясопептонном бульоне образуется равномерное помутнение. Далее отмечается выпадение рыхлого осадка и газообразование.
- При росте на среде Китта-Тароцци бактерии растут с интенсивным газообразованием.
Рис. 17. При росте в 1% сахарном агаре колонии образуются в глубине. У них уплотненный центр, от периферии отходят переплетающиеся нити.
Clostridium septicum синтезируют ряд ферментов. Они живут на различных органических субстратах, в том числе содержащих сахара и аминокислоты с выделением углекислого газа и молекулярного водорода.
Бактерии ферментируют некоторые углеводы: глюкозу, мальтозу и лактозу с образованием газа и кислоты. Нитраты переводят в нитриты. Расщепляют белки с выделением аммиака и сероводорода. Молоко под действием бактерий свертывается медленно. Не разлагают сахарозу, глицерин и маннит. Не образуют индол.
Токсины
Clostridium septicum выделяют 4 экзотоксина: а, р, у и s. обладающие некротическим, гемолитическим и летальным действиями.
Рис. 18. Рост Clostridium septicum на питательных средах.
ССЫЛКИ ПО ТЕМЕ
- Все про бактерии
- Что такое ботулотоксин
- Что такое споры
Статьи раздела «Газовая гангрена»
- Возбудитель газовой гангрены
Самое популярное
- Все о грибке стопы: симптомы и эффективное лечение современными препаратами
- Грибок кожи головы: как распознать и лечить
- Симптомы и лечение грибка ногтей на руках (онихомикоза)
- Польза и вред кишечной палочки
- Как лечить дисбактериоз и восстановить микрофлору
Статьи раздела «Газовая гангрена»
- Вопросы диагностики, лечения и профилактики газовой гангрены
О микробах и болезнях 2019
Профилактика
Мероприятия по профилактике распространения газовой гангрены направлены на предупреждение инфицирования контактных лиц, локализацию очага заболевания и распространение инфекции у больного. Основу профилактики газовой гангрены составляют следующие мероприятия:
- Профилактика охлаждения и отморожения конечностей.
- Большое значение в предупреждении распространения клостридиальной инфекции имеет правильная первичная обработка раны, транспортная иммобилизация, правильное использование кровеостанавливающего жгута.
- Своевременная радикальная хирургическая обработка ран, введение антибиотиков, адсорбированного полианатоксина и противогангренозной сыворотки.
- Осуществление противоэпидемических мероприятий в стационарном отделении.
- При госпитализации больной изолируется в отдельную палату.
- Проводится тщательная обработка операционной (двукратная генеральная уборка).
- Перевязки необходимо проводить в отдельной перевязочной.
- Перевязочный материал подвергается сжиганию, а инструменты — дробной стерилизации. Их необходимо обрабатывать в паровом стерилизации или сухожаровом шкафу.
- Медицинский персонал должен работать только в перчатках, которые после окончания работ сжигаются, либо подвергаются дезинфекции путем погружения в дезинфицирующие растворы карболовой кислоты, лизола или хлорамина.
- Посуда замачивается в 2% растворе гидрокарбоната натрия и кипятится в течение 1,5 часа.
- Постельное белье больного и халаты медперсонала обрабатываются аналогичным образом.
- Осуществление противоэпидемических мероприятий в очаге инфекции.
- После помещения больного в стационар помещение подлежит санитарной обработке. Мебель и кровать больного протираются 6% раствором перекиси водорода с моющем средством. Работать при этом надо только в перчатках, так как 6% раствор перекиси водорода вызывает ожоги на коже!
- Посуда замачивается в 2% растворе гидрокарбоната натрия и кипятится в течение 1,5 часа.
ССЫЛКИ ПО ТЕМЕ
- Как выглядит противочумный костюм
- Все про клостридии
- Аденоиды у детей
- Все про острицы у детей
- Как передается ветрянка
- Все про аспергиллез
Статьи раздела «Газовая гангрена»
- Вопросы диагностики, лечения и профилактики газовой гангрены
Самое популярное
- Все о грибке стопы: симптомы и эффективное лечение современными препаратами
- Грибок кожи головы: как распознать и лечить
- Симптомы и лечение грибка ногтей на руках (онихомикоза)
- Польза и вред кишечной палочки
- Как лечить дисбактериоз и восстановить микрофлору
Статьи раздела «Газовая гангрена»
- Вопросы диагностики, лечения и профилактики газовой гангрены
О микробах и болезнях 2019
Сухой вариант
Сухая гангрена возникает в тканях богатых белком и содержащих мало жидкости. Она чаще развивается у истощенных, худых людей и преимущественно является следствием нарушения кровообращения. Сухая форма некроза развивается постепенно, не проявляя особой склонности к прогрессированию. Примером формирования такого вида омертвения тканей является диабетическая стопа и гангрена ног при сахарном диабете, которые считаются серьезным осложнением этой болезни. Стадии ее при диабете будут рассмотрены ниже в качестве образца течения «сухого» варианта некроза.
Переход сухой формы в «мокрую» возможен уже на начальной стадии болезни
Чтобы избежать подобных последствий, важно не пропустить признаки гангрены и всеми возможными средствами обеспечить предотвращение перехода относительно благоприятной формы, коей является сухая разновидность, в тяжелую и часто опасную для жизни – влажную гангрену. Основными профилактическими мерами в данном случае являются проводимые в асептических условиях регулярные перевязки, позволяющие закрыть места поражения стерильным материалом
Виды гангрены
Различают гангрены сухую и влажную, а также газовую гангрену.
Газовая гангрена
Газовая гангрена — тяжелая раневая инфекция с преимущественным поражением соединительной и мышечной ткани, вызываемыми строгими анаэробами. Этот вид раневой инфекции относится к наиболее опасным для жизни осложнениям ран любого генеза. Отличительной чертой анаэробной инфекции является отсутствие признаков воспаления и превалирование некротических изменений в тканях, развитие выраженного отека и газообразования, сопровождающихся выраженной интоксикацией организма специфическими токсинами и продуктами тканевого распада.
Сухая гангрена
Сухая гангрена развивается при быстром прекращении притока к тканям крови и их высыхании, если в омертвевшую ткань не проникает гнилостная инфекция. Характеризуется высыханием, сморщиванием и уплотнением тканей (пораженная часть уменьшается в объёме), что связано со свёртыванием белков клеток и распадом форменных элементов крови. Омертвевший участок приобретает темно-бурый или чёрный цвет. По внешнему сходству такого участка с мумией процесс, ведущий к формированию сухой гангрены, называется мумификацией.
Прекращение притока крови сопровождается резкой болью в зоне нарушенного кровообращения, конечность бледнеет, становится мраморно-синей и холодной. Пульс и кожная чувствительность исчезают, хотя в глубоколежащих тканях боль держится долго. С периферии омертвение распространяется к центру.Функция пораженной части тела нарушается. Со временем на границе омертвевшей и здоровой ткани развивается реактивное воспаление (демаркационное), ведущее к отторжению омертвевшего участка.
Сухая гангрена локализуется обычно на конечностях, кончике носа и ушных раковинах (особенно при отморожениях и химических ожогах). Проникновение в омертвевшие ткани гнилостной инфекции может вызвать переход сухой гангрены во влажную. Через несколько месяцев омертвевший участок может самостоятельно отторгнуться. При асептическом некрозе внутренних органов происходит постепенное рассасывание омертвевшего участка с замещением его рубцовой тканью или образованием кисты (мышца сердца, мозг). Если реакция соседних с гангренозным участком здоровых тканей вялая, процесс омертвения распространяется и на них. При этом в кровь попадают продукты гнилостного распада, что может привести к тяжёлой интоксикации.
Влажная гангрена
Влажная гангрена характеризуется серовато-бурым цветом пораженного участка, отёчностью тканей и увеличением их объёма. Ткани обычно превращаются в мягкую массу грязно-зелёного цвета, издающую гнилостный запах; в дальнейшем происходит разжижение и распад тканей. При благоприятном течении на границе между здоровыми и мёртвыми тканями намечается чёткая граница. Омертвевшие ткани отторгаются, и образовавшийся дефект заживает с образованием рубца.
Иногда (отсутствие инфекции, ограниченность очага) влажная гангрена может перейти в сухую. Если организм ослаблен, а местная реакция тканей вялая, процесс распространяется, всасывание продуктов гнилостного распада в общий кровоток ведёт к развитию сепсиса (особенно часто у больных диабетом сахарным). При влажной гангрене утрачивается чувствительность в поверхностных слоях пораженных тканей, в более глубоких — боль; температура тела повышается; общее состояние больного тяжёлое.
Вопрос-ответ
Какие микроорганизмы вызывают газовую гангрену?
Газовая гангрена чаще всего вызывается бактериями рода Clostridium, особенно Clostridium perfringens. Эти микроорганизмы анаэробные, то есть могут развиваться в условиях отсутствия кислорода, что делает их особенно опасными в глубоких ранах и травмах.
Каковы основные симптомы газовой гангрены?
Симптомы газовой гангрены включают резкую боль в области пораженной ткани, отек, появление пузырей с газом, а также изменение цвета кожи (потемнение). В некоторых случаях может наблюдаться системная реакция, такая как высокая температура и озноб.
Как проводится лечение газовой гангрены?
Лечение газовой гангрены включает хирургическое удаление некротических тканей, антибиотикотерапию и, в некоторых случаях, гипербарическую оксигенацию для подавления роста анаэробных бактерий. Важно начать лечение как можно раньше для предотвращения серьезных осложнений.
Советы
СОВЕТ №1
Обратите внимание на ранние симптомы газовой гангрены, такие как резкая боль в области раны, отек и изменение цвета кожи. При их появлении незамедлительно обращайтесь за медицинской помощью, так как ранняя диагностика может спасти жизнь.
СОВЕТ №2
Следите за чистотой и обработкой любых ран и повреждений кожи. Правильная дезинфекция и уход за ранами помогут предотвратить инфекцию и снизить риск развития газовой гангрены.
СОВЕТ №3
Если у вас есть хронические заболевания, такие как диабет, контролируйте их состояние и регулярно проходите медицинские осмотры. Это поможет снизить риск осложнений, связанных с инфекциями, включая газовую гангрену.
СОВЕТ №4
Обучите себя и своих близких основам первой помощи. Знание того, как правильно реагировать на травмы и инфекции, может значительно повысить шансы на успешное лечение и избежать серьезных последствий.